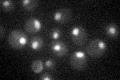
YIL063C

View description
Protein of unknown function involved in nuclear processes of the Ran-GTPase cycle; involved in nuclear protein export; contains Ran Binding Domain and FxFG repeats; interacts with Srm1p, GTP-Gsp1p, Rna1p and Crm1p; is not essential
Localization:
Intensity:
Fold change:
Significance:
-
C’ GFP library in SD

nucleus27.89 -
N' NOP1pr-GFP in SD

nucleus135.093 -
N' TEF2pr-mCherry in SD

nucleus207.739 -
N' NATIVEpr-GFP in SD

nucleus39.4498 -
N' TEF2pr-VC and Cyto-VN in SD

#N/A0 -
C’ GFP library in SD+DTT

nucleus28.811.03No -
C’ GFP library in SD+H2O2

nucleus24.250.86No -
C’ GFP library in Starvation Media
nucleus24.980.89No -
C’ GFP library on the background of Pup2-DaMP

nucleus -
C’ GFP library on the background of CCT mutant

nucleus34.60541.24034No
